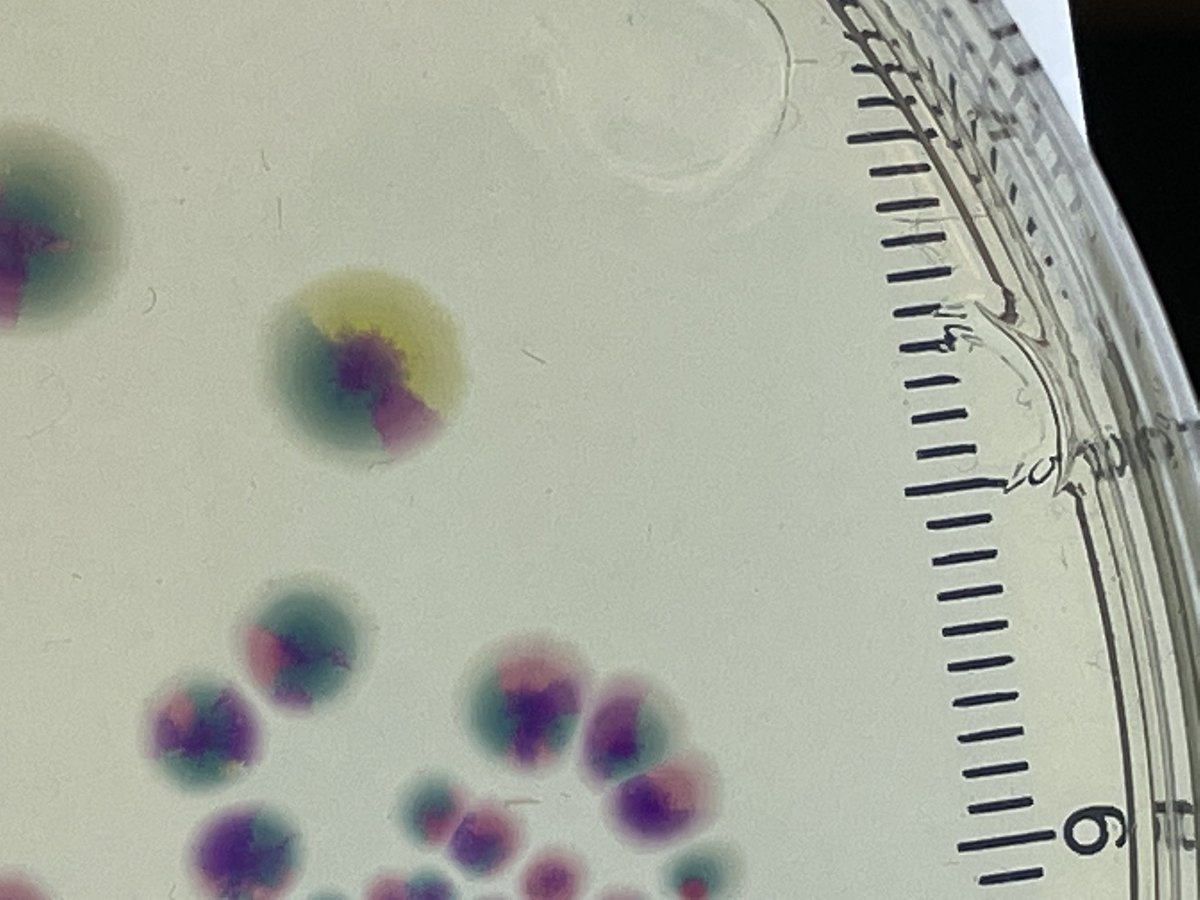
Mark O. Martin tweet media

Calling all early-career researchers! The @CureArthritis 2025 grants are open for applications on Nov 4. From Psoriatic Arthritis to Pediatric Rheumatology, these grants fund game-changing research. Apply today: CureArthritis.org/Research-Grants #ArthritisResearch #Rheumatology
English